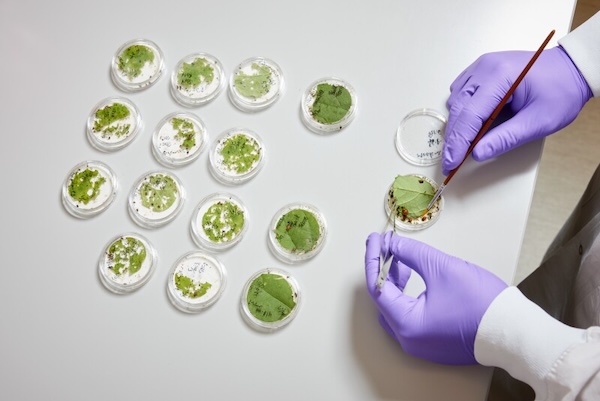

After four years in stealth mode, “Terran Biosciences” has emerged with a plan to use its RNA-based technology platform to develop a host of potential applications for protecting and enhancing crops. The company says 15 product candidates are already in development and it has already demonstrated proof-of-concept in corn, soybeans, and tomatoes.
Rather than altering a plant’s genome (aka, genetically modified crops), Terrana aims to essentially “program” plants with precise biological instructions via sprays and seed treatments. “Think of it like software,” says CEO Ryan Rapp. “You can stick a floppy disk or USB drive into the computer and give it a set of instructions. This is the first time we’ve had a platform where we can actually do this in plants.”
Terrana says its RNA technology — which involves using ribonucleic acid molecules to influence or control biological processes — enables products to be applied either topically or as seed treatments. After the product is sprayed onto crops, the RNA chassis enters the plant through tiny tears in the leaves and delivers the RNA cargo to plant cells. The cargo could act on its own to stimulate a plant’s immune response and fight off viruses, or it could be translated into proteins that help the plant, such as “Cry proteins,” which kill leaf-eating insects.
Rapp says Terrana’s RNA-based platform will allow it to develop products at a much faster rate than conventional transgenic (genetically modified) and ag chemical approaches. “We can go from having an idea to testing something in a plant in 30-days,” Rapp told Agri Investor. “It is orders of magnitude faster than the technologies that we’re dealing with in the industry today.”
The first product expected to reach the market is an antiviral spray for tomatoes, targeting North America and Mexico first, and later expanding to Europe and North Africa. Additional pipeline candidates are being developed for corn and soybean. Rapp notes that Brazil farmers are spraying up to 16 times a year to control soybean rust and other pathogens. “We think that with our product, we can potentially help them reduce that to a single spray per crop cycle.”
Beyond crop protection, Terrana is also eying plant improvements. Rapp uses cherry trees and the warming climate in the Pacific Northwest as an example. He notes that the trees require a long period of cold hours below 45 degrees every winter in order to flower and set high-quality fruit. In theory, Rapp says it would be possible to create a spray that can adjust plants’ temperature requirements and allow them to still flower and set fruit, even if temperatures stay high.
Terrana’s technology is inspired by RNA-based approaches originally developed for human health. In fact, it was launched by Flagship Pioneering, the same company behind RNA-based vaccine maker “Moderna.” Flagship has committed an initial $50 million to scale operations and develop the first products. Learn more at the Terrana Bioscience website HERE. (Sources: AgTech Navigator, Chemical & Engineering News)